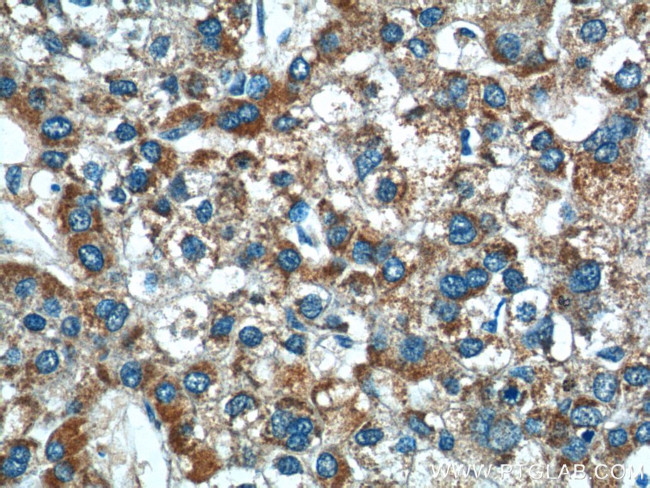
AGTR1 Antibody in Immunohistochemistry (Paraffin) (IHC (P))

Search
Proteintech
AGTR1 Polyclonal Antibody
{{$productOrderCtrl.translations['antibody.pdp.commerceCard.promotion.promotions']}}
{{$productOrderCtrl.translations['antibody.pdp.commerceCard.promotion.viewpromo']}}
{{$productOrderCtrl.translations['antibody.pdp.commerceCard.promotion.promocode']}}: {{promo.promoCode}} {{promo.promoTitle}} {{promo.promoDescription}}. {{$productOrderCtrl.translations['antibody.pdp.commerceCard.promotion.learnmore']}}
产品信息
25343-1-AP
种属反应
已发表种属
宿主/亚型
分类
类型
抗原
偶联物
形式
浓度
规格
纯化类型
保存液
内含物
保存条件
运输条件
产品详细信息
Immunogen sequence: IAYFNNCLN PLFYGFLGKK FKRYFLQLLK YIPPKAKSHS NLSTKMSTLS YRHSDNVSSS TKKPAPCFEV E (290-359 aa encoded by BC022447)
靶标信息
AGTR1 is known as Angiotensin II Type 1 Receptor. Angiotensin II is a potent vasopressor hormone and a primary regulator of aldosterone secretion. It is an important effector controlling blood pressure and volume in the cardiovascular system. And it acts through at least two types of receptors. This gene encodes the type 1 receptor which is thought to mediate the major cardiovascular effects of angiotensin II. Moreover, this gene may play a role in the generation of reperfusion arrhythmias following restoration of blood flow to ischemic or infarcted myocardium. It was previously thought that a related gene, denoted as AGTR1B, existed; however, it is now believed that there is only one type 1 receptor gene in humans. Multiple alternatively spliced transcript variants have been reported for this gene.
仅用于科研。不用于诊断过程。未经明确授权不得转售。
生物信息学
蛋白别名: Angiotensin II type-1 receptor; Angiotensin II type-1 receptor A; angiotensin II type-1A receptor; angiotensin receptor 1; angiotensin receptor 1a; AT1 receptor; AT1 receptor A; AT1AR; AT1BR; Type-1 angiotensin II receptor; Type-1 angiotensin II receptor A; type-1A angiotensin II receptor; type-1B angiotensin II receptor; unnamed protein product; vascular type-1 angiotensin II receptor
基因别名: 1810074K20Rik; AG2S; Agtr-1a; AGTR1; AGTR1A; AGTR1B; AI551199; Angtr-1a; AT1; AT1A; AT1AR; AT1B; AT1BR; AT1R; AT2R1; AT2R1A; AT2R1B; ATR1; HAT1R
UniProt ID: (Human) P30556, (Rat) P25095, (Mouse) P29754
Entrez Gene ID: (Human) 185, (Rat) 24180, (Mouse) 11607